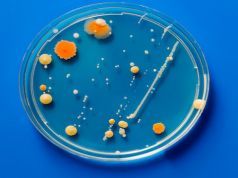
Protect Yourself from These Three Foodborne Bacteria

Always Check the Label of Your Supplements for This
Are your supplements up to snuff? You might have read recent news articles about the shockingly low standards of many supplements on the market...
7 Benefits of Balancing Your Chakras, and How to Do It
If you feel like you never have enough energy, making an effort to tone out distractions and tune into your body may be the...
9 Natural Ways to Remove Liver Spots and Age Spots
Have you noticed any spots of darker color on your face, hands or chest? Those brown spots that form on the skin as we...
Protect Yourself from These Three Foodborne Bacteria
Multistate food poisoning outbreaks seem to be more common these days — it feels like we’re always reporting on some new E. coli outbreak....
Blood Pressure Control Takes New Form, Improving Quality of Life
How low can you go when it comes to your blood pressure? Research from the National Institutes of Health (NIH) suggests that treating those...
McDonald’s Opens Franchise in Historic Chinese Villa, Sparking Outrage
McCafé with a side of McHistory has sparked outrage and controversy among Chinese citizens this month, as fast-food chain Mcdonald’s opens a franchise café...
Cycling Could Save the World — Plus, It’s Healthy!
A recent report, published this month by the University of California, Davis, outlines significant findings in support of transportation cycling. Transportation cycling is all...
Mother Loses Infant Daughter Over Tea
Marijuana use for medicinal and therapeutic reasons has increased in recent years, with bills to legalize the drug rolling out in individual states on...
47 Percent of Americans with High Blood Pressure at Severe Risk
Having uncontrolled high blood pressure is exceedingly dangerous, and may increase your risk for fatal or severe nonfatal cardiovascular events, including heart attack and...
This 3,000-Year-Old Treatment Could Help Your Pet Heal
Some people will do anything for their pets, but acupuncture? Is this part of a crazy new trend or just a modern application of...